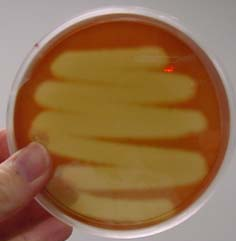
<p>What type of hemolysis is this?</p>
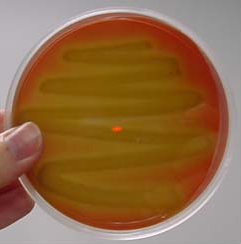
<p>What type of hemolysis is this?</p>
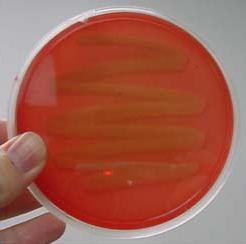
<p>What type of hemolysis is this?</p>

Lecture 6. Colony morphology
1/12
There's no tags or description
Looks like no tags are added yet.
Name | Mastery | Learn | Test | Matching | Spaced | Call with Kai |
|---|
No study sessions yet.
13 Terms
α-hemolysis
Partial clearing of blood that results in a green discoloration of the medium
β-hemolysis
Complete clearing of blood cells around the colonies
What type of hemolysis is this?
Beta hemolysis
What type of hemolysis is this?
Alpha hemolysis
What type of hemolysis is this?
Gamma hemolysis
Swarming edges of colonies are described as:
Hazy blanket of growth on the media surface (ex: Proteus spp.)
Yeast colony edges are described as:
Creamy white to yellowish with “feet” or “pedicules”
What are the types of colony elevation?
Raised
Convex
Flat
Umbilicate
Umbonate
Umbilicate elevation
Convex with depressed center (pitting S. pneumoniae if no polysaccharide capsule)
Umbonate elevation
Raised or bulging center, convex
What pigment does Pseudomonas aeruginosa give off?
Green or green metallic sheen (“oil slick”)
The microbiologist should never inhale odor directly from the plate
True
P. aeruginosa gives off what kind of odor?
Fruity or grapelike